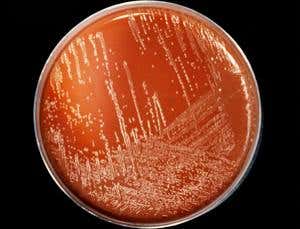
New Scientist. Science news and long reads from expert journalists, covering developments in science, technology, health and the environment on the website and the magazine.

Deadly work (Image: CNRI/SPL/Getty Images)
A researcher in the US has died of a disease caused by the bacteria he was studying. The tragedy highlights the dangers of research on human respiratory germs. Research on airborne mutants of H5N1 bird flu is currently under an indefinite moratorium, partly over fears of just such laboratory infections.
Richard Din was working on Neisseria meningitidis at the Veterans Health Research Institute in San Francisco. The bacteria live harmlessly in the noses of 10 per cent of people, especially teenagers. Yet some strains cause meningitis or blood infection – sepsis – in 1.2 million people a year worldwide when inhaled.
Din had a fever, headache and chills on the evening of 27 April, and went to hospital the next morning after developing a rash. He died just 17 hours after symptoms started. He had been infected by the same strain of meningococcus as the one he worked with – serogroup B.
Advertisement
Meningococcus deaths have plummeted in recent years because of vaccines against four common serogroups, but there is no broadly protective vaccine for serogroup B. Din’s lab is working on that.
Tragically, a vaccine that could have saved him, developed by another group of researchers, is only a few months away. Swiss-based company Novartis expects to license Bexsero, the first general vaccine against serogroup B, later this year. Other serogroup B vaccines are also in the works.
High-risk job
Meningococcus is notorious for lab infections. After two US lab workers died in 2000, the US Centers for Disease Control and Prevention found that microbiology staff who handle the bacteria are at 65 times greater risk of getting the disease than the general population. And whereas 10 to 20 per cent of all cases result in death, half of those infected in a lab die. Either the lab bacteria are fiercer, or the lab staff inhale more of them.
In 2008, the UK Health and Safety Executive urged security upgrades after finding that most of the 27 known meningococcal laboratory-acquired infections since 1985 followed work at open lab benches rather than laminar flow hoods – semi-enclosed boxes that constantly suck air inwards to keep microbes from wafting onto researchers. In 2010, a researcher in France survived meningococcal sepsis after a hood malfunctioned.
The more dangerous a pathogen is, the greater the biosecurity level (BSL) of a lab needs to be if researchers are to study the germ. “Hospital labs handle it at BSL2, the second-lowest level of containment,” says Michael Levin at Imperial College London, because simple clinical cultures pose little more risk than natural exposure. But research labs grow and manipulate more bacteria, so British researchers work at BSL3. “Everything is done in hoods.”
Yet accidents still happen. Initial checks on Din’s lab found no malfunctions. A student in Levin’s lab was infected by a minor spill inside a working hood, but she recovered.
Flu fears
A fear of lab infections is just one of the issues that have held up the publication of work on lethal H5N1 bird flu that can spread readily between mammals.
Michael Osterholm at the University of Minnesota, Minneapolis, and others opposing full publication fear it will lead to similar work in other labs, where lab infections could release the viruses to the community. Din’s friends and colleagues are being treated to keep them safe and stop them spreading bacteria. Flu would be harder to contain, says Osterholm.
“Our security precautions render human infection virtually impossible,” says Ab Osterhaus, head of the lab in Rotterdam, the Netherlands, that did one of two controversial H5N1 experiments. “There are no laminar flows that could malfunction, but negatively pressurised, completely closed glove boxes”, plus numerous other precautions, and independent inspection.
“I’m sure the Rotterdam lab is safe,” Osterholm agrees. “But what worldwide standards do we have to make sure every lab is like them?” The World Health Organization may now review H5N1 research rules worldwide, but cannot impose standards.
Din’s death demonstrates the choice facing researchers: working on pathogens could be dangerous, but the natural diseases that the research aims to fight are definitely dangerous.
“The trade-off between security and progress must err on the side of caution,” says Peter Openshaw, head of the Centre for Respiratory Disease at Imperial College London, “but rare events like this sometimes mean the rules get tightened too far, slowing research that might save lives.”
Topics:




